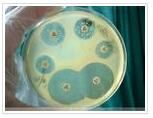
土麴黴 土麴黴

相關詞條
-
土麴黴酸
鏇光度[α]D22-16.6°(在1%氯仿中)。 m(係數6230)。 thom.)的培養液分離而得。
-
土麴黴原變種
菌落在查氏瓊脂25℃7天直徑27- 45mm,10- 12天45- 60mm;菌落在麥芽汁瓊脂上25℃7天直徑40- 45mm,10天可達55- 60m...
形態特徵 生境 中國分布 世界分布 模式產地 -
土麴黴金色變種
菌落淺黃色,短絨毛狀,中心略凸起,有放射狀溝紋;營養菌絲樹根狀,分叉,有隔,分生孢子梗較長;分生孢子,孢子橢圓;生長較快,於30℃兩天可長滿平皿。
形態特徵 生境 中國分布 世界分布 模式產地 -
赭麴黴毒素
赭麴黴毒素包括7種結構類似的化合物,結構通式:R1=Cl或H;R2=H、CH3或C2H5。其中赭麴黴毒素A(R1=C1,R2=H)毒性最大,在霉變穀物、...
簡介 歷史 性質 臨床症狀 殘留 -
棲土麴黴
菌落在查氏瓊脂上25℃7天直徑36-37mm,12-14天45mm;質地絲絨狀至絮狀,中央分呈厚絮狀,具不明顯的輻射狀溝紋;菌落在查氏酵母膏瓊脂上25℃...
形態特徵 中國分布 模式產地 特點 -
麴黴屬
叢梗孢目(Moniliales)叢梗孢科中的一屬。營養體是分隔的菌絲。分生孢子梗直接由營養菌絲產生,分枝形成分生孢子梗的細胞稱作足細胞。
簡介 分布種類 特徵 -
臭麴黴
菌落在查氏瓊脂上25℃培養10天直徑40-60mm;具有黃色或白色至黃色的菌絲體和大量的輻射狀溝紋;菌落在查氏酵母膏瓊脂上生長較快,25℃7天直徑54-60mm。
形態特徵 生境 中國分布 世界分布 模式產地 -
匍匐麴黴
中文綱名 Sphaeropsidales Aspergillus
匍匐麴黴